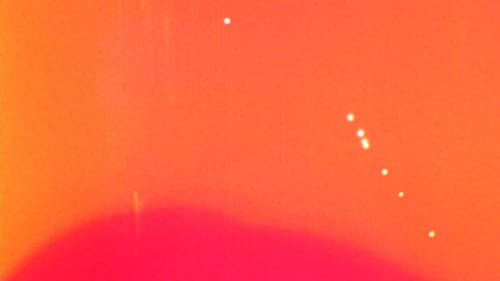
13 Bild 1

13
8.5202011 Min.Regie: Shinya Isobe
Teilen:
Wo streamen?
Leider sind keine Streaming-Informationen für Deutschland verfügbar.
Bilder
Community-Bewertung
-/10(0 Stimmen)
Deine Bewertung:
1 Bewertung pro Tag möglich
Kommentare
Logge dich ein, um einen Kommentar zu schreiben.